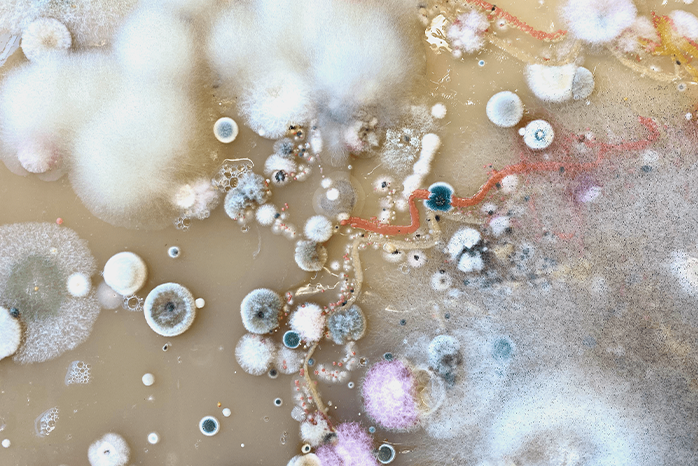

The Ladislav Sutnar Faculty of Design and Art, also known as ‘Sutnarka’, is a modern art school where students earn Bachelor's, Master's, and Ph.D. degrees in design and applied art.
Located in a state-of-the-art building with unique studios, the faculty boasts a team of renowned artists and designers. Students consistently succeed in Czech and international competitions, collaborate with global professional partners, and participate in various exhibitions.
Following the example of top international schools, the Sutnar Faculty emphasizes new trends, integrating design, technology, and research to provide innovative, socially beneficial solutions.
As part of the University of West Bohemia in Pilsen, the faculty offers multidisciplinary cooperation with other UWB faculties and research centers, guided by experienced professionals. Continuing the legacy of Czech-American designer Ladislav Sutnar, the faculty manages the prestigious Ladislav Sutnar Gallery, showcasing works by artists such as Robert Rauschenberg and Frank Malina.
For 15 years, the faculty has organized ArtCamp, a major international summer art school in Central Europe. It also holds the largest collection and archive of Ladislav Sutnar's works in Europe and annually awards the Ladislav Sutnar Prize to distinguished personalities and institutions in design and art. Sutnarka is a symbol of excellence, reflected in the achievements of its teachers, students, and graduates.